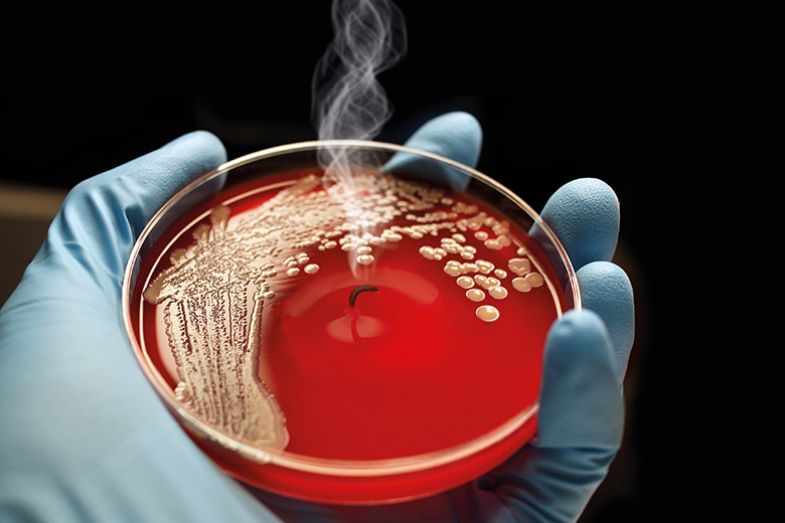

When Carlo Croce – for decades, one of the giants of US cancer research – read a story about his science on the front page of The New York Times, he decided to sue.
The lengthy exposé, published in March 2017, detailed how the celebrated Italian-born scientist with more than 1,000 peer-reviewed papers to his name had faced multiple allegations of research misconduct over many years. At least 30 papers on which he was an author contained improperly manipulated western blots, which often indicate whether an experiment has succeeded or failed, the story explained. Some 20 of his papers had received notices from journals – including corrections and retractions – but his employer, Ohio State University, had not acted, it added.
The stakes were high. As department chair, Croce drew an annual salary of more than $800,000 (£631,290) – a reflection of the fact that his Columbus laboratory had won more than $29.1 million in federal grants.
Any mistakes in figures were “honest errors”, he argued, laying the blame largely on junior researchers or collaborators who did the hands-on work. And he filed a lawsuit against both the newspaper itself and the individual reporters involved in the story for defamation and emotional distress.
But his legal action did not just target The New York Times. Croce also sued David A. Sanders, a virologist and associate professor at Purdue University, quoted in the article, who criticised some of Croce’s papers in particularly strong terms. In a writ submitted to an Ohio court in June 2017, Sanders is alleged to have “made defamatory statements with actual malice, and wrongful and wilful intent to injure Dr Croce”. His “outrageous and intolerable” conduct had caused Croce to suffer “serious mental anguish and personal humiliation”, the writ continues, arguing that Croce is entitled to “punitive damages” from Sanders.
Croce’s claim against The New York Times was dismissed – a decision upheld by an appeal court in July, which found that the story was not defamatory. But the case against Sanders rumbles on.
While the episode is unusual, it is not unique. Academia may have historically proceeded on the basis that robust academic criticism of colleagues is all part of the job description and not an issue for the courts, but a handful of cases suggest that this understanding may no longer apply. In another case from 2017, Mark Z. Jacobson, a Stanford University engineering professor who has called for 100 per cent renewable energy, launched a $10 million libel claim against Christopher Clack, the founder and chief executive of a data analysis company called Vibrant Clean Energy and the first author of a Proceedings of the National Academy of Sciences paper arguing that Jacobson’s claims for clean energy were overstated and based on unfounded assumptions and errors. Jacobson, who also listed PNAS as a defendant, withdrew his lawsuit a few months later amid criticism, saying, in an interview with Retraction Watch, that he had expected the journal to settle and print a correction.
For many, such lawsuits are an aggressive attempt to intimidate critics into silence, chilling debate that is vital for scientific progress. For others, however, legal redress has become a necessary part of a scholar’s armoury when protecting their hard-won reputations, particularly against accusations from “data vigilantes” operating outside the traditional avenues of post-publication review, often anonymously on websites where scurrilous stories can go viral and wreck careers.
For legal reasons, Sanders is unwilling to discuss his ongoing case, but he is unequivocal about the impact of such actions. “There can be no doubt that the resort to lawsuits and even just the threat of lawsuits or the fear of lawsuits has a grossly distorting effect on the robustness of scientific debate,” Sanders tells Times Higher Education.
“People are being inhibited from exposing [alleged] misconduct because of the fear that it will damage their careers...Invoking the legal system to fight scientific battles is a generally pusillanimous approach,” he says, dismissing it as a “strategy employed by those who wish to evade directly confronting the scientific evidence”.
As a scientist willing to put his name publicly to concerns, Sanders remains a rarity. Nearly all concerns over research results or potential breaches of research integrity are made either confidentially to the journals where research was published or, increasingly, on the PubPeer website, where comments can be posted anonymously. While many credit this online forum and similar sites for revealing many instances of erroneous research and misconduct, Sanders see problems with a culture where anonymity is dominant and “revealing violations of scientific norms becomes an endeavour that is driven underground. Refusing to associate one’s name with the claims that one is making because of the fear of legal repercussions [is] also detrimental practice.”
Moreover, even those posting pseudonymously may not be immune from legal action, it seems. In March 2015, a Michigan judge ordered PubPeer to hand over identifying information for a commenter after the site was sued by cancer researcher Fazlul Sarkar, then at Wayne State University, who claimed that a job offer from another university was withdrawn as a result of critical comments. That decision, however, was overturned by a Michigan appeals court in December 2016 when a trio of judges decided that Sarkar was “not entitled to unmask the identities of any speakers…due to the anonymity protections afforded by the First Amendment” – a decision hailed by PubPeer as a “critical victory for freedom of speech and scientific inquiry”.
The case was widely regarded as a failure on several fronts – with the initial action revealing only that the commenter was Claire Francis, a pseudonymous whistleblower known for sending hundreds of email complaints to editors of scientific journals, heads of institutions and journalists. The case also brought to light a Wayne State investigation into Sarkar, which recommended the retraction of 42 publications and revealed it had ruled that 204 of 263 allegations against him “constituted substantiated misconduct”. Gaining the moniker as the “researcher who sued PubPeer” also brought significant attention to the subsequent retraction of many of Sarkar's papers, with Retraction Watch currently listing 41 retractions and placing him ninth in its list of most-retracted authors.
While many scientists might regard such legal shenanigans with distaste, they are not entirely unexpected given the passions involved in science, believes Fiona Godlee, editor-in-chief of medical journal The BMJ. “Science has had a history of big, combative characters pushing aggressively for their ideas – science isn’t always argued in a careful and dispassionate way,” she explains. Individuals who take uncomfortably forceful positions are sometimes even rewarded for pushing so hard, Godlee observes. “It was clear at the time that characters like Darwin and Huxley were right, but we now admire them for the way they argued,” she explains, adding she “can see why scientists might turn to law [when] science is increasingly competitive and social media allows people to denigrate others”.
Indeed, legal action might be a reasonable avenue of last resort, in exceptional cases, to correct the scientific record, reflects Godlee. With competing and conflicting scientific claims found on different sites, “it is often difficult to see who is right and who is wrong”. For this reason, she welcomed a 2012 libel suit launched against her and The BMJ by Andrew Wakefield, the British doctor struck off the UK medical register in 2010 for “dishonest, irresponsible and...callous behaviour” in conducting a study into supposed links between the MMR vaccine and autism, published in 1998 in The Lancet.
“I felt rather pleased to be sued in this case,” recalls Godlee of the action, which objected to a story by investigative reporter Brian Deer and an accompanying editorial by Godlee claiming that Wakefield’s research on the MMR vaccine was fraudulent.
“We had hoped we would get him into court because he had a history of suing but not going to court,” says Godlee, who believes a definitive ruling “would have been helpful” to lay to rest any lingering concerns that Wakefield had been unfairly victimised. In the end, however, the journal “spent a huge amount defending the action” only for a Texas judge to throw out the case on the grounds that his court had no jurisdiction over the defendants.
The action was filed in Texas because it was where Wakefield lived at the time, but his choice may be questioned on tactical as well as jurisdictional grounds given that US libel law is famously less stringent than English law. England's Defamation Act of 2013 – instigated, in part, by the British Chiropractic Association’s ultimately unsuccessful attempt to sue Guardian writer Simon Singh – has since levelled the playing field a little. In particular, Godlee notes, it offers qualified legal privilege to peer-reviewed statements, making it easier for journals to fend off libel challenges to the papers they publish. However, she adds, there is a “grey area” about what constitutes peer review and, therefore, whether the privilege extends to editorials and investigative journalism.
Moreover, headline-grabbing lawsuits are merely the tip of the iceberg when it comes to the chilling effect of legal threats, Sanders warns. With careers on the line if misconduct is even implied in corrections or retractions, many titles are now reluctant to call out bad behaviour, says Sanders.
“I have encountered editors at numerous journals who fail to take appropriate actions on clear infractions of academic standards because of the fear of the legal ramifications of their actions,” he says. “In one case, a threat of a lawsuit resulted in a reneging on a promise to retract an article.”
One example is plagiarism. According to Sanders, editors are “terrified” of using that word “even in cases where plagiarism is obvious because that term may indicate the existence of misconduct and they are apprehensive of the legal consequences of stating that one or more of the authors of an article committed misconduct,” he adds. As a result, they resort to euphemisms, such as “textual overlap”, continues Sanders, as this suggests plagiarism but “the possibility is left open that it was unintentional”.
Adopting such circumspect practices, while infuriating researchers keen for a public reckoning, may be a wise move. In October 2017, an appeals court in Spain ruled in favour of Miguel Delibes, a professor at the Spanish National Research Council, in a libel action against Elsevier. Although the judge ruled that Delibes should accept the publisher’s decision to retract his 2009 commentary exploring “sexually specific infanticide” in bears from the journal Animal Behaviour, he agreed that Elsevier used “untruthful and unverified” language in the 2011 retraction notice. Delibes told Retraction Watch that the judgment “confirmed that my honourability had been damaged” by the false accusation in the original retraction notice, which claimed that the authors had “misappropriated data, plagiarized and concealed the authorship” of previously published work. The notice was updated to state that the work was done “without proper cross-referencing”.
The fact that, in an international academic environment, publishers are open to libel threats in any number of legal systems – some in more litigant-friendly jurisdictions even than England’s – has implications for the reliability of the scientific record, Sanders believes: “In most cases, the correction and retraction notices for articles are obfuscatory, probably with the goal of reducing the legal liability of the publishers.”
In 2011, for instance, Nature retracted a flawed 2004 paper by UCL immunologist Tony Segal. But it failed to mention that the paper had been withdrawn at his request after he discovered that his then-postdoctoral researcher Jatinder Ahluwalia had interfered with the results of experiments. In 2009, a formal inquiry by UCL had concluded beyond reasonable doubt that Ahluwalia had misrepresented his experiments by deliberately altering the numbering of computer files containing results. However, Ahluwalia’s refusal to sign the retraction opened up the journal to a legal challenge – prompting UCL to publish the report in full.
“The full details of all investigations like this should be made public because it clarifies what happened,” says Segal, adding that “only by dealing in an entirely transparent way can you stop this kind of thing happening again.”
However, a team of researchers from the US National Library of Medicine found in 2017 that editorial expressions of concern were becoming an increasingly popular way for journals to flag potentially problematic papers, as opposed to correcting or retracting them. Most of these expressions of concern “have not led to retractions or corrections, and many remain unresolved”, they note in the paper, “Concern noted: a descriptive study of editorial expressions of concern in PubMed and PubMed Central”, published in Research Integrity and Peer Review.

The supposed weakening of journals’ policing of research misconduct, however, is not a scenario recognised by Virginia Barbour, a former chief editor of PLoS Medicine and co-chair of the Committee on Publication Ethics.
“My experience has been, at least in the Australian sector, that universities take their responsibilities in this area very seriously, as do journals,” says Barbour, who is now director of the Australasian Open Access Strategy Group. Nor do legal issues contribute substantially to delays in retracting papers, she adds. “If there is a failure or slowness to correct the published record it is more often for logistical reasons, such as ongoing complex issues in cases that can’t lead to one paper being corrected until a whole body of work has been examined.”
Her view is echoed by Chris Graf, director of research integrity and publishing ethics at Wiley and another past co-chair of COPE. “Retraction notices are clear and, if anything, are becoming more detailed,” Graf insists. He suspects that the dissatisfaction with them may be caused by a misunderstanding of their purpose. “Retraction notices are not about punishing authors – they are there to correct the literature when articles are seriously flawed or use the wrong data,” he explains.
Indeed, he believes that using retraction notices to browbeat errant scientists would undermine efforts to encourage research integrity because “it is good science to address honest errors and then give kudos to those who admit mistakes. One of the big blockers to research integrity is fear – that if you retract a paper then people will look differently at you, even if you did a brilliant thing in retracting.”
Only about 60 per cent of retraction notices actually concern research fraud, according to a Science analysis published in 2018, Graf notes: “Journals must ensure their content is as reliable as [it] can be, and should correct the scientific record…but we should avoid statements that libel or defame.”
Yet this reticence is precisely what has caused some scholars to lose patience with journals and to post their suspicions about published papers on the internet without waiting for the correction process to take its long and frequently unsatisfying course.
“It seems like you need to provide 100 times the evidence to retract an article than to get something published in the first place,” says Nick Brown, a graduate student in psychology at the University of Groningen in the Netherlands, whose personal blog lists dozens of examples of potentially flawed research papers in his discipline. Together with James Heathers, a postdoctoral researcher in behavioural science at Northeastern University in Boston, he has probed numerous instances of questionable data. These include research by psychologist Nicolas Guéguen, whose high-profile 2014 study purporting to show that men find women in high heels sexier was retracted at the request of his institution, the University of South Brittany, in October, a full four years after the duo reported their concerns to the journal Archives of Sexual Behavior.
Brown was dubbed a “data thug” in a Science profile last year for his uncompromising approach to calling out dubious outcomes. But he insists that “truth is an absolute defence to libel [actions], so our claims are based on verifiable facts”. He is “very careful and triple-checks everything”, and sticks mostly to pointing out authors’ most egregious errors; he is not always able to ascribe misconduct, but “if someone has copied and pasted large amounts of text into their work, there are few defences [for] that”, he says. He also confines himself to targets that are “fairly low level”, adding that he and Heathers “keep our ambitions modest and don’t shout too loudly”.
Other whistleblowing bloggers have not always trodden so carefully when it comes to legal action, Brown reflects. Science Fraud – founded in 2012 as a clearing site for anonymous allegations – was unlikely to last long given its incendiary name, he says. It closed after less than a year amid a tide of legal threats, with its unmasked founder, Paul Brookes, a professor at the University of Rochester Medical Center in New York, admitting to THE that the name was “probably a bad move”. The perceived void that it left was filled by PubPeer.
Meanwhile, the For Better Science website, run by molecular biologist-turned-journalist Leonid Schneider, takes aim at some of science’s biggest names and institutions in a fearless, perhaps reckless, manner, in pursuit of a mission to expose the “fraud and ethics breaches that are routinely covered up”. Many scientists will attest to Schneider's nose for a story, but his need to ask readers to donate to his legal defence fund reflects the cost of such an approach. “I am a court-convicted criminal [on the basis of] two appeal hearings,” Schneider tells THE. These cases cost him up to €40,000 (£34,875) and €12,000 in legal expenses to defend, he confides. Adding to his “toxic” legal jeopardy is a threat of prison still hanging over him. “I was also threatened with lawsuits by the University of Ferrara – who reported me to the state prosecutor – and even the government of France,” he adds.

Some sites do, however, seem to manage the task of reporting widely on research infractions without running up crippling legal bills. Retraction Watch is a popular site that reports on retractions but also does its own reporting into the background to them and is an obvious target for those who do not want misconduct allegations against them circulated. Yet while “we do get threats on occasion telling us to take down a post, it has never led to anything”, says science journalist Adam Marcus, the site’s co-founder with colleague Ivan Oransky.
In Marcus’ view, journals are also doing a decent job of standing firm. “It is fair to say that, on occasion, journals have been reluctant to retract a paper because of litigation, but they will reserve retraction for cases where it is absolutely necessary,” he says. The annual number of retractions would seem to bear this out, he adds, having plateaued at about 1,400 annually for several years, up from about 40 cases in the early 2000s.
Launching a libel action is also, in most territories, a risky and costly exercise, Marcus observes. “It is very expensive to sue and most people don’t have the time or money for this,” he says. It is a particularly bad move for those who lose. In 2015, for instance, Ranjit Kumar Chandra, a doctor accused of fraud and financial deception by the Canadian Broadcasting Corporation, was ordered to pay the broadcaster just over C$1.6m (£800,000) in costs after losing his bid for $137 million in damages.
As such, Marcus is unconvinced that there is a growing appetite among academics to instruct law firms against publishers or fellow scholars when their research is contested.
But one area of research that could be particularly prone to legal action is, ironically, one directly inspired by concerns about sloppy and unethical science. So-called reproducibility initiatives are a recent innovation that ask researchers to attempt to replicate prominent experiments in their fields in an attempt to shore up the rigour of the scientific process. But Brian Nosek, co-founder and director of the Centre for Open Science, which has coordinated several such projects, is well aware of the “potential for legal action” if failed reproduction efforts resulted in the “nuclear option” of alleging misconduct.
“We’ve had seven years of experience. There has been a lot of anger, contention and some accusations of impropriety, but we have not had anyone threaten litigation,” he says. “Even those who are most unhappy with the reproducibility movement, who find our results upsetting, accept that this is part of the research process. If critiques focus on the content of research and don’t become personalised, people generally can accept the scholarship, however critical.”
On the other hand, when scholarly disagreement leads to rancour and allegations of bad faith, even the most patient of scientists may resort to the law. Edzard Ernst, the former professor of complementary medicine at the University of Exeter, had numerous acrimonious run-ins with alternative medical practitioners during his long career applying scientific methods to testing their claims. But he was content to give as good as he got – except on two occasions when he was castigated in the press over claims – which he vigorously denies – that he leaked a report into the cost-effectiveness of funding alternative medicine on the UK's National Health Service. Even then, his legal threats saw the claim withdrawn in only one of the two cases.
“Libel action – or the threat of it – is sometimes the only measure that gets results,” Ernst reflects. “Yet, I would advise great caution and reserve this only for the most desperate of cases.”
Register to continue
Why register?
- Registration is free and only takes a moment
- Once registered, you can read 3 articles a month
- Sign up for our newsletter
Subscribe
Or subscribe for unlimited access to:
- Unlimited access to news, views, insights & reviews
- Digital editions
- Digital access to THE’s university and college rankings analysis
Already registered or a current subscriber?








